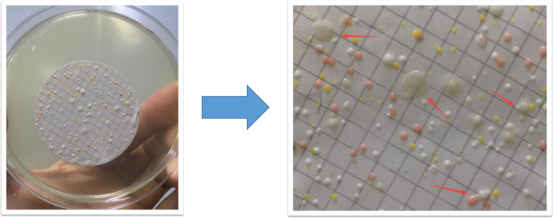

Microbiological Filter: One of the Most Widely Used Membranes in Analytical and Research Applications.
2025-04-08
MS
42
What Are Microbiological Filter?
Membrane Solutions®(MS®) supply a series of microbiological filter which are using in obstruct -ing microorganism by different pore size, for enriching or analysis.
The filters are available in Micro discTM (Individual pack) and Micro flmTM (Continuous pack).
The filters are made of Mixed cellulose Ester (MCE) Grid-ded Membrane Filter, which are composed of Cellulose Acetate and Cellulose Nitrate. Because MCE membrane is biologically inert, it’s one of the most widely used membranes in analytical and research applications. MCE Membrane Filter is characterized by a smoother and more uniform surface than pure nitrocellulose filter.
What are the Features About MS® microbiological filter
- High recovery rates for microorganisms
- Comply to ISO7704:2023
- Bacterial Challenge: LRV>7
- Excellent Flow rate for different liquids
- Microbiological ”friendly” ink promotes growth on grids to maximize recovery
- Presterilization by Gamma Ray.
- Detailed Quality Certificate offered in each batch
Why MCE Membrane and How to Choose Pore Size?
MCE membranes is a mixture of cellulose nitrate and cellulose acetate which allows effective retention with high-flow rates and optimal colony growth.
0.22 μm: Brevundimonas diminuta (ATCC 19146)
0.45 μm: Serratia marcescens (ATCC 14756)
0.65 μm: Candida albicans (ATCC10231)
0.8 μm: Aspergillus niger (ATCC16404)

What is the Filtration Step of the Grid Membrane Filters ?
①Economical Filtration System-
Grid membrane filter+manifold+pump
②MS Single Use Filtration System-
Bioset monitor ( Grid membrane filter ) + petri dish + manifold + pump
What Are The Advantages of Microbiological Filter?
Membrane Solutions High Performance MCE membrane uses microbiological – “friendly” ink which promotes growth on grids to maximize recovery
– No enhancement or inhibition by the grid lines
– No enhancement or inhibition due to chemical extractables
– No enhancement or inhibition by the sterilization process
Ordering Information
MicrodiscTM Individual Pack
|
Part Number Description Pack Size Pcs/pack |
||
|
MFMCE047022GWS |
MCE Gridded Membrane Filter, white, black grid, sterile, 0.22μm, 47mm |
100 |
|
MFMCE047045GWS |
MCE Gridded Membrane Filter, white, black grid, sterile, 0.45μm, 47mm |
100 |
|
MFMCE047080GWS |
MCE Gridded Membrane Filter, white, black grid, sterile, 0.80μm, 47mm |
100 |
|
|
MCE Gridded Membrane Filter, white, black grid, sterile, 1.0μm, 47mm |
100 |
|
MFMCE050022GWS |
MCE Gridded Membrane Filter, white, black grid, sterile, 0.22μm, 50mm |
100 |
|
MFMCE050045GWS |
MCE Gridded Membrane Filter, white, black grid, sterile, 0.45μm, 50mm |
100 |
|
MFMCE050080GWS |
MCE Gridded Membrane Filter, white, black grid, sterile, 0.80μm, 50mm |
100 |
|
MFMCE050100GWS |
MCE Gridded Membrane Filter, white, black grid, sterile, 1.0μm, 50mm |
100 |
|
MFCN047022GWS |
CN Gridded Membrane Filter, white, black grid, sterile, 0.22μm, 47mm |
100 |
|
MFCN047045GWS |
CN Gridded Membrane Filter, white, black grid, sterile, 0.45μm, 47mm |
100 |
|
MFCN047080GWS |
CN Gridded Membrane Filter, white, black grid, sterile, 0.80μm, 47mm |
100 |
|
MFCN047100GWS |
CN Gridded Membrane Filter, white, black grid, sterile, 1.0μm, 47mm |
100 |
|
MFCN050022GWS |
CN Gridded Membrane Filter, white, black grid, sterile, 0.22μm, 50mm |
100 |
|
MFCN050045GWS |
CN Gridded Membrane Filter, white, black grid, sterile, 0.45μm, 50mm |
100 |
|
MFCN050080GWS |
CN Gridded Membrane Filter, white, black grid, sterile, 0.80μm, 50mm |
100 |
|
MFCN050100GWS |
CN Gridded Membrane Filter, white, black grid, sterile, 1.0μm, 50mm |
100 |
|
MFPES047022GWS |
PES Gridded Membrane Filter, white, black grid, sterile, 0.22μm, 47mm |
100 |
|
MFPES047045GWS |
PES Gridded Membrane Filter, white, black grid, sterile, 0.45μm, 47mm |
100 |
|
MFMCE047045GBS |
MCE Gridded Membrane Filter, black, white grid, sterile, 0.45μm, 47mm |
100 |
|
MFMCE047022GWSP |
MCE Gridded Membrane Filter+Absorbent pad, white, black grid, sterile, 0.22μm, 47mm |
50 |
|
MFMCE047045GWSP |
MCE Gridded Membrane Filter+Absorbent pad, white, black grid, sterile, 0.45μm, 47mm |
50 |
|
MFMCE047080GWSP |
MCE Gridded Membrane Filter+Absorbent pad, white, black grid, sterile, 0.80μm, 47mm |
50 |
|
MFMCEH047045GWS |
MCE Gridded Membrane Filter, high-flow,white, black grid, sterile, 0.45µm, 47mm |
100 |
|
MFMCE047022SP |
MCE Membrane Filter+Absorbent pad, white, sterile, 0.22µm, 47mm |
100 |
|
MFMCE047045SP |
MCE Membrane Filter+Absorbent pad, white, sterile, 0.45µm, 47mm |
100 |
|
MFMCE047080SP |
MCE Membrane Filter+Absorbent pad, white, sterile, 0.80µm, 47mm |
100 |
|
MFMCE047100SP |
MCE Membrane Filter+Absorbent pad, white, sterile, 1.0µm, 47mm |
100 |
|
MFPES047022GBS |
PES Gridded Membrane Filter, black, white grid, sterile, 0.22µm, 47mm |
100 |
|
MFPES047045GBS |
PES Gridded Membrane Filter, black, white grid, sterile, 0.45µm, 47mm |
100 |
|
MFMCE047045GBS |
MCE Gridded Membrane Filter, black, white grid, sterile, 0.45µm, 47mm |
100 |
|
MFMCE047022SP |
MCE Membrane Filter+Absorbent pad, white, sterile, 0.22µm, 47mm |
100 |
|
MFMCE047045SP |
MCE Membrane Filter+Absorbent pad, white, sterile, 0.45µm, 47mm |
100 |
|
MFMCE047080SP |
MCE Membrane Filter+Absorbent pad, white, sterile, 0.80µm, 47mm |
100 |
|
MFMCE047100SP |
MCE Membrane Filter+Absorbent pad, white, sterile, 1.0µm, 47mm |
100 |
MicrofilmTM Continuous Pack
Compatible with MS ® Automatic Membrane Dispenser
|
Part Number Description Pack Size Pcs/pack |
||
|
MFMCE047045CWM |
MCE Gridded Membrane Filter, white, black grid, sterile, 0.45µm, 47mm, compatible with MS® Automatic Membrane Dispenser, Microsart™ e.motion Dispenser |
150 |
|
MFMCE047022CWM |
MCE Gridded Membrane Filter, white, black grid, sterile, 0.22µm, 47mm, compatible with MS® Automatic Membrane Dispenser, Microsart™ e.motion Dispenser |
150 |
|
MFMCE047080CWM |
MCE Gridded Membrane Filter, white, black grid, sterile, 0.80µm, 47mm, compatible with MS® Automatic Membrane Dispenser, Microsart™ e.motion Dispenser |
150 |
|
MFMCE050022CWM |
MCE Gridded Membrane Filter, white, black grid, sterile, 0.22µm, 50mm, compatible with MS® Automatic Membrane Dispenser, Microsart™ e.motion Dispenser |
150 |
|
MFMCE050045CWM |
MCE Gridded Membrane Filter, white, black grid, sterile, 0.45µm, 50mm, compatible with MS® Automatic Membrane Dispenser, Microsart™ e.motion Dispenser |
150 |
|
MFMCE050080CWM |
MCE Gridded Membrane Filter, white, black grid, sterile,0.8µm, 50mm, compatible with MS® Automatic Membrane Dispenser, Microsart™ e.motion Dispenser |
150 |
|
MFMCE050100CWM |
MCE Gridded Membrane Filter, white, black grid, sterile,1.0µm, 50mm, compatible with MS® Automatic Membrane Dispenser, Microsart™ e.motion Dispenser |
150 |
|
MFMCE047045CB |
MCE Gridded Membrane Filter, black, white grid, sterile, 0.45µm, 47mm, compatible with MS® Automatic Membrane Dispenser, Microsart™ e.motion Dispenser |
150 |
|
MFMCE047045CWM-MLB |
MCE Gridded Membrane Filter, white, black grid, sterile, 0.45µm, 47mm, compatible with MS® Automatic Membrane Dispenser, Millipore EZ-Pak curve dispenser |
150 |
|
MFCN050022CWM |
CN Gridded Membrane Filter, white, black grid, sterile, 0.22µm, 50mm, compatible with MS® Automatic Membrane Dispenser, Microsart™ e.motion Dispenser |
150 |
|
MFCN050045CWM |
CN Gridded Membrane Filter, white, black grid, sterile, 0.45µm, 50mm, compatible with MS® Automatic Membrane Dispenser, Microsart™ e.motion Dispenser |
150 |
|
MFCN050080CWM |
CN Gridded Membrane Filter, white, black grid, sterile, 0.8µm, 50mm, compatible with MS® Automatic Membrane Dispenser, Microsart™ e.motion Dispenser |
150 |
|
MFPES047045CWM |
PES Gridded Membrane Filter, white, black grid, sterile, 0.45µm, 47mm, compatible with MS® Automatic Membrane Dispenser, Microsart™ e.motion Dispenser |
150 |
|
MFPES047022CWM |
PES Gridded Membrane Filter, white, black grid, sterile, 0.22µm, 50mm, compatible with MS® Automatic Membrane Dispenser, Microsart™ e.motion Dispenser |
150 |
|
MFPES047045CBM |
PES Gridded Membrane Filter, black, white grid, sterile, 0.45µm, 47mm, compatible with MS® Automatic Membrane Dispenser, Microsart™ e.motion Dispenser |
150 |
Conclusion
For more detailed insights and inquiries about MCE Gridd membrane filters,please visit the Membrane Solutions website m.zsxmh.com. You can leave a message or follow us for updates on our latest products and innovations. We’re here to assist you with your filtration needs and provide tailored solutions that meet your specific requirements. Don’ t hesitate to reach out!

MFMCE047100GWS
MFMCE047100GWS